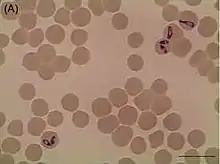

| Babesia caballi | |
|---|---|
![]() | |
| Babesia caballi in vitro culture | |
| Scientific classification | |
| Domain: | Eukaryota |
| Clade: | Diaphoretickes |
| Clade: | SAR |
| Clade: | Alveolata |
| Phylum: | Apicomplexa |
| Class: | Aconoidasida |
| Order: | Piroplasmida |
| Family: | Babesiidae |
| Genus: | Babesia |
| Species: | B. caballi |
| Binomial name | |
| Babesia caballi (Nuttall & Strickland, 1910) | |
Babesia caballi is a species belonging to Alveolata and the family Babesiidae. In horses, it causes the babesiosis disease, called "equine babesiosis". Its length is 2.5-5 µm, while its width is 2 µm. It is usually oval-shaped. Its vector and second feeders are ticks. In North America B. caballi is being spread by Dermacentor nitens.
Bibliography
- Furmaga, Stanisław (1983). Choroby pasożytnicze zwierząt domowych. Warsaw: Państwowe Wydawnictwo Rolnicze i Leśne. ISBN 978-83-09-00671-8.
- Griffiths, Henry Joseph (1978). A handbook of veterinary parasitology : domestic animals of North America. Minneapolis: University of Minnesota Press. ISBN 978-0-8166-0828-7.
This article is issued from Wikipedia. The text is licensed under Creative Commons - Attribution - Sharealike. Additional terms may apply for the media files.